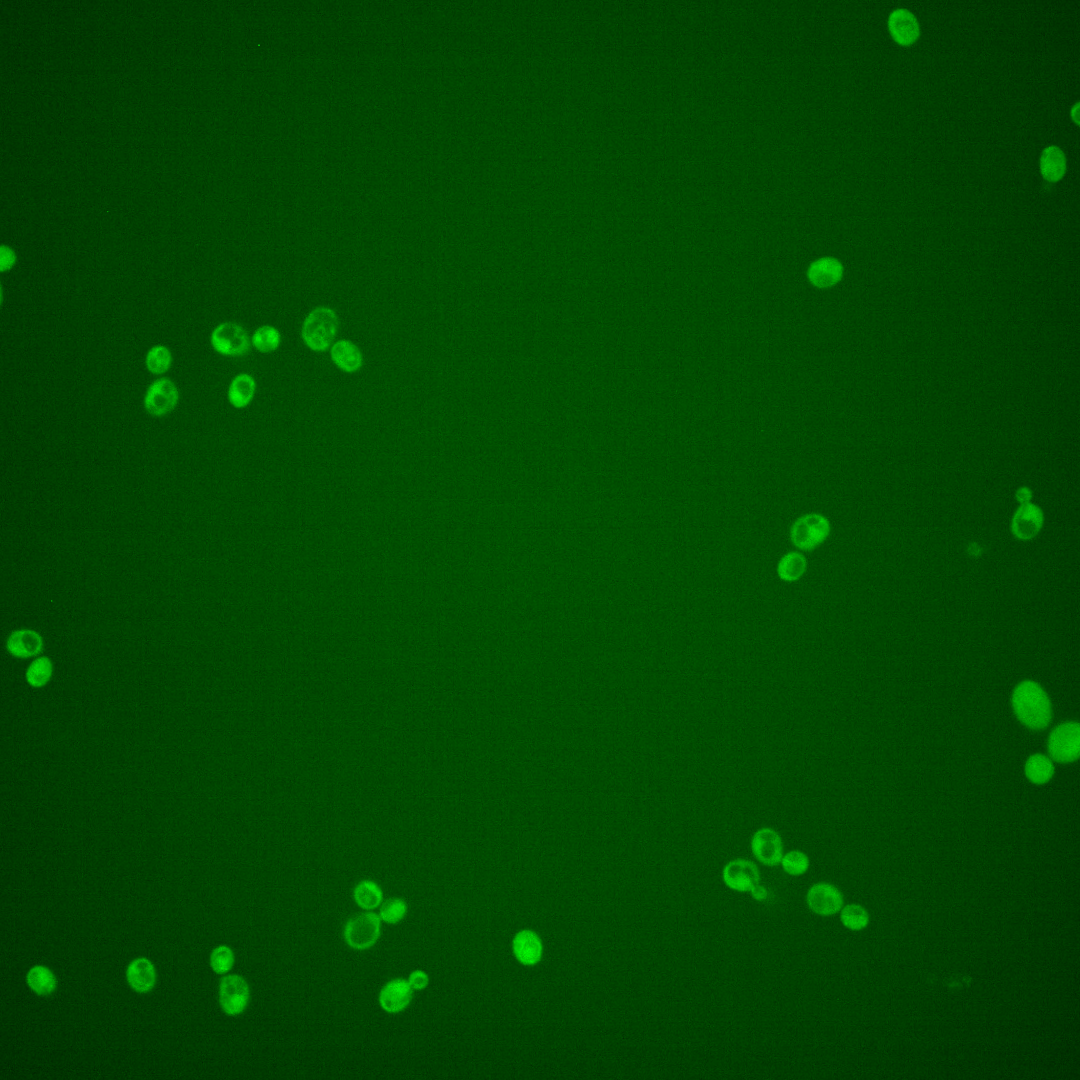
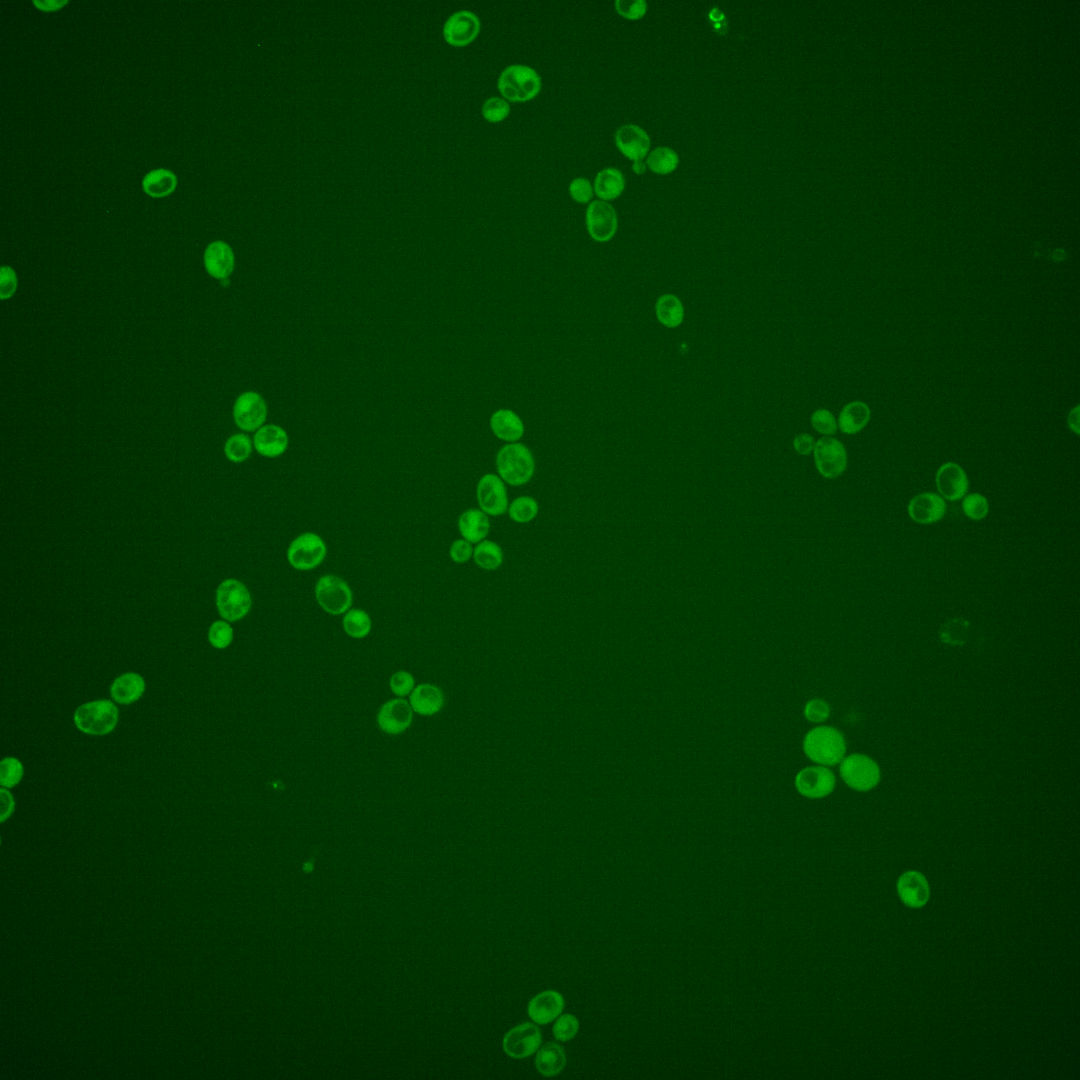

| Standard name | |
|---|---|
| Human Ortholog | |
| Description | Serine/threonine protein kinase; involved in sphingolipid-mediated signaling pathway that controls endocytosis; activates Ypk1p and Ykr2p, components of signaling cascade required for maintenance of cell wall integrity; contains a PH-like domain; redundant with Pkh1p; PKH2 has a paralog, PKH1, that arose from the whole genome duplication |
Micrographs




















































































Sub-cellular Localization
Yeast GFP Assignment
Protein Abundance
Localization Change
External localization resources
| ensLOC | DeepLoc | |||||||||||||||||||||||
|---|---|---|---|---|---|---|---|---|---|---|---|---|---|---|---|---|---|---|---|---|---|---|---|---|
| Localization | WT1 | WT2 | WT3 | RAP60 | RAP140 | RAP220 | RAP300 | RAP380 | RAP460 | RAP540 | RAP620 | RAP700 | HU80 | HU120 | HU160 | rpd3Δ_1 | rpd3Δ_2 | rpd3Δ_3 | WT1 | WT2 | WT3 | AF100 | AF140 | AF180 |
| Cortical Patches | 3 | 1 | 0 | 1 | 1 | 0 | 1 | 2 | 2 | – | 3 | 3 | 3 | 3 | 2 | 0 | 0 | 1 | 16 | 16 | 21 | 2 | 1 | 3 |
| Bud | 2 | 1 | 5 | 3 | 3 | 10 | 7 | 11 | 8 | – | 16 | 14 | 2 | 3 | 10 | 0 | 0 | 0 | 1 | 0 | 1 | 1 | 2 | 8 |
| Bud Neck | 1 | 1 | 5 | 1 | 0 | 1 | 4 | 3 | 0 | – | 0 | 1 | 0 | 3 | 0 | 6 | 4 | 4 | 6 | 11 | 8 | 0 | 0 | 2 |
| Bud Site | 0 | 0 | 0 | 0 | 0 | 2 | 0 | 1 | 2 | – | 4 | 0 | 0 | 0 | 1 | 0 | 0 | 0 | – | – | – | – | – | – |
| Cell Periphery | 6 | 25 | 14 | 6 | 9 | 16 | 7 | 7 | 13 | – | 15 | 22 | 17 | 22 | 27 | 6 | 9 | 10 | 9 | 25 | 38 | 2 | 1 | 2 |
| Cytoplasm | 190 | 336 | 218 | 197 | 257 | 234 | 365 | 463 | 246 | – | 200 | 151 | 202 | 262 | 317 | 346 | 230 | 387 | 144 | 272 | 97 | 136 | 168 | 252 |
| Endoplasmic Reticulum | 5 | 2 | 0 | 0 | 1 | 0 | 0 | 0 | 3 | – | 2 | 8 | 2 | 1 | 2 | 39 | 9 | 23 | 8 | 3 | 4 | 1 | 0 | 3 |
| Endosome | 1 | 0 | 0 | 0 | 1 | 1 | 1 | 0 | 0 | – | 0 | 0 | 0 | 0 | 1 | 4 | 5 | 6 | 7 | 2 | 2 | 0 | 0 | 2 |
| Golgi | 0 | 0 | 0 | 0 | 0 | 0 | 0 | 0 | 0 | – | 0 | 0 | 0 | 0 | 0 | 5 | 0 | 1 | 4 | 1 | 2 | 1 | 0 | 3 |
| Mitochondria | 0 | 5 | 1 | 7 | 17 | 60 | 101 | 147 | 144 | – | 157 | 191 | 0 | 0 | 9 | 17 | 4 | 4 | 20 | 12 | 28 | 2 | 3 | 5 |
| Nucleus | 0 | 0 | 0 | 0 | 0 | 2 | 3 | 4 | 0 | – | 1 | 2 | 0 | 0 | 0 | 1 | 2 | 0 | 0 | 0 | 0 | 0 | 0 | 0 |
| Nuclear Periphery | 0 | 0 | 0 | 1 | 1 | 0 | 1 | 1 | 1 | – | 0 | 0 | 0 | 0 | 0 | 0 | 0 | 0 | 0 | 0 | 0 | 0 | 0 | 0 |
| Nucleolus | 0 | 0 | 0 | 0 | 0 | 0 | 0 | 0 | 0 | – | 1 | 0 | 0 | 0 | 0 | 1 | 0 | 0 | 0 | 0 | 0 | 0 | 0 | 0 |
| Peroxisomes | 0 | 0 | 0 | 0 | 1 | 3 | 5 | 0 | 5 | – | 7 | 3 | 0 | 1 | 0 | 1 | 0 | 0 | 1 | 0 | 0 | 0 | 0 | 0 |
| SpindlePole | 0 | 1 | 1 | 0 | 2 | 4 | 8 | 14 | 10 | – | 6 | 3 | 0 | 2 | 0 | 2 | 3 | 1 | 1 | 0 | 0 | 0 | 0 | 1 |
| Vac/Vac Membrane | 2 | 0 | 1 | 0 | 0 | 1 | 1 | 0 | 0 | – | 0 | 0 | 0 | 0 | 0 | 9 | 8 | 4 | 3 | 5 | 3 | 1 | 1 | 2 |
| Unique Cell Count | 202 | 343 | 224 | 199 | 271 | 267 | 430 | 557 | 340 | 320 | 304 | 209 | 268 | 325 | 370 | 246 | 399 | 226 | 355 | 215 | 151 | 185 | 291 | |
| Labelled Cell Count | 210 | 372 | 245 | 216 | 293 | 334 | 504 | 653 | 434 | 412 | 398 | 226 | 297 | 369 | 437 | 274 | 441 | 226 | 355 | 215 | 151 | 185 | 291 | |
Yeast GFP Assignment
Protein Abundance
| Screen | WT1 | WT2 | WT3 | RAP60 | RAP140 | RAP220 | RAP300 | RAP380 | RAP460 | RAP540 | RAP620 | RAP700 | HU80 | HU120 | HU160 | rpd3Δ_1 | rpd3Δ_2 | rpd3Δ_3 | AF100 | AF140 | AF180 |
|---|---|---|---|---|---|---|---|---|---|---|---|---|---|---|---|---|---|---|---|---|---|
| Mean Cell GFP Intensity (1e-4) | 5.2 | 4.2 | 4.0 | 3.8 | 4.0 | 3.7 | 3.5 | 3.6 | 3.2 | – | 3.3 | 3.0 | 5.0 | 4.9 | 4.2 | 5.9 | 6.7 | 6.4 | 4.9 | 4.9 | 5.4 |
| Std Deviation (1e-4) | 0.6 | 0.7 | 0.9 | 1.3 | 1.2 | 1.2 | 1.2 | 1.3 | 0.8 | – | 1.2 | 0.7 | 1.2 | 1.4 | 1.2 | 2.3 | 3.2 | 2.8 | 1.1 | 1.4 | 1.4 |
| Intensity Change (Log2) | – | – | – | -0.09 | -0.0 | -0.14 | -0.19 | -0.14 | -0.34 | – | -0.29 | -0.44 | 0.33 | 0.29 | 0.08 | 0.55 | 0.73 | 0.66 | 0.3 | 0.3 | 0.42 |
Localization Change
| Localization | RAP60 | RAP140 | RAP220 | RAP300 | RAP380 | RAP460 | RAP540 | RAP620 | RAP700 | HU80 | HU120 | HU160 | rpd3Δ_1 | rpd3Δ_2 | rpd3Δ_3 |
|---|---|---|---|---|---|---|---|---|---|---|---|---|---|---|---|
| Actin | – | – | – | – | – | – | – | – | – | – | – | – | – | – | – |
| Bud | – | – | – | – | – | – | – | – | – | – | – | – | – | – | – |
| Bud Neck | – | – | – | – | – | – | – | – | – | – | – | – | – | – | – |
| Bud Site | – | – | – | – | – | – | – | – | – | – | – | – | – | – | – |
| Cell Periphery | – | – | – | – | – | – | – | – | – | – | – | – | – | – | – |
| Cyto | – | – | – | – | – | – | – | – | – | – | – | – | – | – | – |
| Endoplasmic Reticulum | – | – | – | – | – | – | – | – | – | – | – | – | – | – | – |
| Endosome | – | – | – | – | – | – | – | – | – | – | – | – | – | – | – |
| Golgi | – | – | – | – | – | – | – | – | – | – | – | – | – | – | – |
| Mitochondria | – | – | – | – | – | – | – | – | – | – | – | – | – | – | – |
| Nuclear Periphery | – | – | – | – | – | – | – | – | – | – | – | – | – | – | – |
| Nuc | – | – | – | – | – | – | – | – | – | – | – | – | – | – | – |
| Nucleolus | – | – | – | – | – | – | – | – | – | – | – | – | – | – | – |
| Peroxisomes | – | – | – | – | – | – | – | – | – | – | – | – | – | – | – |
| SpindlePole | – | – | – | – | – | – | – | – | – | – | – | – | – | – | – |
| Vac | – | – | – | – | – | – | – | – | – | – | – | – | – | – | – |
| Cortical Patches | – | – | – | – | – | – | – | – | – | – | – | – | – | – | – |
| Cytoplasm | – | – | – | – | – | – | – | – | – | – | – | – | – | – | – |
| Nucleus | – | – | – | – | – | – | – | – | – | – | – | – | – | – | – |
| Vacuole | – | – | – | – | – | – | – | – | – | – | – | – | – | – | – |
External localization resources
Images






























Protein Concentration and Protein Localization Data
| R1 | R2 | R3 | ||||||||||||||||
|---|---|---|---|---|---|---|---|---|---|---|---|---|---|---|---|---|---|---|
| G1 Pre-START | G1 Post-START | S/G2 | Metaphase | Anaphase | Telophase | G1 Pre-START | G1 Post-START | S/G2 | Metaphase | Anaphase | Telophase | G1 Pre-START | G1 Post-START | S/G2 | Metaphase | Anaphase | Telophase | |
| Concentration | 1.5313 | 1.7288 | 1.5554 | 1.5432 | 1.1487 | 1.4912 | 3.8016 | 2.2932 | 2.0074 | 2.2374 | 1.4506 | 1.6647 | 2.855 | 2.2502 | 2.4206 | 2.1388 | 1.9058 | 2.1806 |
| Actin | 0.0512 | 0.0044 | 0.0073 | 0.0018 | 0.0014 | 0.0126 | 0.141 | 0.0132 | 0.0065 | 0.0212 | 0.0088 | 0.0007 | 0.0303 | 0.0102 | 0.019 | 0.0118 | 0.0082 | 0.0087 |
| Bud | 0.0023 | 0.0036 | 0.0059 | 0.0006 | 0.0005 | 0.0008 | 0.0024 | 0.0012 | 0.0015 | 0.0019 | 0.0133 | 0.0002 | 0.0011 | 0.0007 | 0.0002 | 0.0006 | 0.0017 | 0.0002 |
| Bud Neck | 0.0033 | 0.001 | 0.0101 | 0.003 | 0.0004 | 0.006 | 0.0146 | 0.0004 | 0.0003 | 0.001 | 0.0012 | 0.0006 | 0.0004 | 0.0009 | 0.0002 | 0.0023 | 0.0031 | 0.0012 |
| Bud Periphery | 0.0052 | 0.0039 | 0.0067 | 0.0025 | 0.0027 | 0.0021 | 0.0039 | 0.0021 | 0.0016 | 0.0035 | 0.0256 | 0.0004 | 0.0018 | 0.0015 | 0.0004 | 0.0023 | 0.0021 | 0.0005 |
| Bud Site | 0.0033 | 0.0274 | 0.0128 | 0.0008 | 0.0002 | 0.0005 | 0.008 | 0.0096 | 0.0147 | 0.0024 | 0.0051 | 0 | 0.0032 | 0.0137 | 0.0018 | 0.0072 | 0.003 | 0.0002 |
| Cell Periphery | 0.0053 | 0.0056 | 0.007 | 0.0045 | 0.0013 | 0.0021 | 0.0025 | 0.0083 | 0.0012 | 0.001 | 0.0014 | 0.0002 | 0.0138 | 0.0058 | 0.003 | 0.0078 | 0.0044 | 0.0013 |
| Cytoplasm | 0.257 | 0.3944 | 0.3851 | 0.2831 | 0.3873 | 0.4724 | 0.2317 | 0.4029 | 0.3771 | 0.4366 | 0.405 | 0.5056 | 0.5062 | 0.3661 | 0.3101 | 0.3201 | 0.5128 | 0.4755 |
| Cytoplasmic Foci | 0.0159 | 0.0076 | 0.0121 | 0.0328 | 0.0037 | 0.0113 | 0.0228 | 0.0081 | 0.0135 | 0.0057 | 0.0142 | 0.0027 | 0.0042 | 0.0067 | 0.0033 | 0.0095 | 0.0447 | 0.0054 |
| Eisosomes | 0.0017 | 0.001 | 0.001 | 0.0006 | 0.0003 | 0.0003 | 0.0019 | 0.0005 | 0.0002 | 0.0003 | 0.0001 | 0.0001 | 0.0005 | 0.0009 | 0.0003 | 0.0012 | 0.0002 | 0.0002 |
| Endoplasmic Reticulum | 0.0061 | 0.0041 | 0.0063 | 0.0018 | 0.0026 | 0.0041 | 0.0217 | 0.003 | 0.003 | 0.0071 | 0.0033 | 0.0018 | 0.0027 | 0.0024 | 0.0024 | 0.005 | 0.0043 | 0.0023 |
| Endosome | 0.0121 | 0.0012 | 0.0042 | 0.0053 | 0.0125 | 0.0056 | 0.0512 | 0.0028 | 0.0126 | 0.0475 | 0.0295 | 0.0006 | 0.004 | 0.0006 | 0.0006 | 0.0013 | 0.0179 | 0.0022 |
| Golgi | 0.004 | 0.0006 | 0.0009 | 0.0008 | 0.0008 | 0.0021 | 0.0155 | 0.0029 | 0.0177 | 0.0251 | 0.0086 | 0.0001 | 0.0029 | 0.0008 | 0.0011 | 0.0008 | 0.0078 | 0.0026 |
| Lipid Particles | 0.0071 | 0.0016 | 0.0021 | 0.0038 | 0.0013 | 0.0044 | 0.0213 | 0.0023 | 0.0041 | 0.0074 | 0.0005 | 0.0002 | 0.0016 | 0.0009 | 0.0006 | 0.0024 | 0.007 | 0.0008 |
| Mitochondria | 0.0021 | 0.0006 | 0.001 | 0.001 | 0.0052 | 0.0017 | 0.0354 | 0.0015 | 0.0051 | 0.0676 | 0.0117 | 0.0001 | 0.002 | 0.0003 | 0.0002 | 0.0004 | 0.012 | 0.0088 |
| None | 0.5881 | 0.5335 | 0.5279 | 0.6494 | 0.5368 | 0.452 | 0.2201 | 0.535 | 0.5335 | 0.354 | 0.4633 | 0.4858 | 0.4166 | 0.5853 | 0.6542 | 0.6237 | 0.3589 | 0.4881 |
| Nuclear Periphery | 0.0116 | 0.0005 | 0.0009 | 0.0003 | 0.0109 | 0.006 | 0.0915 | 0.002 | 0.0003 | 0.003 | 0.001 | 0.0002 | 0.0012 | 0.0003 | 0.0003 | 0.0005 | 0.0008 | 0.0005 |
| Nucleolus | 0.0011 | 0.001 | 0.0013 | 0.0003 | 0.001 | 0.0032 | 0.0025 | 0.0001 | 0.0001 | 0.0004 | 0.0002 | 0 | 0.0003 | 0.0003 | 0.0001 | 0.0002 | 0.0002 | 0 |
| Nucleus | 0.0047 | 0.002 | 0.0026 | 0.0004 | 0.0034 | 0.0057 | 0.0695 | 0.0004 | 0.0002 | 0.0011 | 0.001 | 0.0002 | 0.0007 | 0.0005 | 0.0004 | 0.0004 | 0.0009 | 0.0002 |
| Peroxisomes | 0.0053 | 0.0004 | 0.0008 | 0.005 | 0.0002 | 0.0013 | 0.013 | 0.0018 | 0.0055 | 0.0022 | 0.0024 | 0 | 0.0018 | 0.0005 | 0.0009 | 0.0009 | 0.0019 | 0.0005 |
| Punctate Nuclear | 0.0075 | 0.0043 | 0.0021 | 0.001 | 0.0003 | 0.0027 | 0.0151 | 0.0005 | 0.0003 | 0.0008 | 0.0006 | 0.0002 | 0.003 | 0.0007 | 0.0004 | 0.0003 | 0.0058 | 0.0002 |
| Vacuole | 0.0038 | 0.0011 | 0.0018 | 0.0011 | 0.0124 | 0.0023 | 0.0065 | 0.0009 | 0.0007 | 0.0064 | 0.0022 | 0.0003 | 0.0015 | 0.0008 | 0.0005 | 0.0012 | 0.0016 | 0.0005 |
| Vacuole Periphery | 0.0012 | 0.0001 | 0.0002 | 0.0001 | 0.0149 | 0.0008 | 0.0079 | 0.0003 | 0.0002 | 0.0038 | 0.0009 | 0 | 0.0002 | 0.0001 | 0 | 0.0001 | 0.0005 | 0.0002 |
Sequencing Data
| R1 | R2 | |||||||||
|---|---|---|---|---|---|---|---|---|---|---|
| G1 Post-START | S/G2 | Metaphase | Anaphase | Telophase | G1 Post-START | S/G2 | Metaphase | Anaphase | Telophase | |
| Gene Expression | 6.2887 | 4.5581 | 7.8921 | 11.4218 | 8.8146 | 8.1537 | 13.7493 | 12.857 | 13.7472 | 12.8494 |
| Translational Efficiency | 0.6277 | 0.9461 | 0.5037 | 0.3783 | 0.4082 | 0.7389 | 0.4622 | 0.4822 | 0.4527 | 0.4399 |
Hit Data
| Dataset | Hit |
|---|---|
| Protein Concentration | ✘ |
| Protein Localization | ✘ |
| Gene Expression | ✘ |
| Translational Efficiency | ✘ |
Endocytosis
| Temp | Actin Patch (Sac6-tdTomato) | Cortical Patch (Sla1-GFP) | Late Endosome (Snf7-GFP) | Vacuole (Vph1-GFP) |
|---|---|---|---|---|
| 37℃ | ||||
| RT |
Cell Cycle Omics
CYCLoPs (Pkh2-GFP)
| Gene / Allele | Actin Patch (Sac6-tdTomato) | Cortical Patch (Sla1-GFP) | Late Endosome (Snf7-GFP) | Vacuole (Sac6-tdTomato) |
|---|
| Gene | Images |
|---|
| Gene | Images |
|---|
Images are not yet available
Images are not yet available